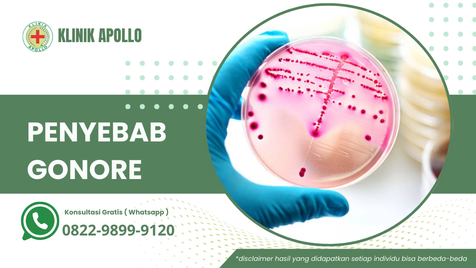

Gonore atau kencing nanah di sebabkan oleh bakteri Neisseria gonorrhoeae. Infeksi tersebut bisa menyebar lewat hubungan seksual secara penetrasi, dubur, dan mulut. Untuk pria yang terinfeksi tak perlu sampai ejakulasi untuk menularkan.
Sedangkan ibu hamil yang tengah menderita penyakit ini dapat menularkan pada bayinya lewat persalinan secara normal. Di pastikan bahwa seseorang tidak mudah terkena jika menyentuh benda, seperti dudukan pada toilet.

>>> Hubungi kami untuk konsultasi online, [ Gratis ]
Penjelasan dan Penularan Gonore
Gonore, juga dikenal sebagai kencing nanah, adalah infeksi menular seksual (IMS) yang disebabkan oleh bakteri Neisseria gonorrhoeae.
Infeksi ini dapat mempengaruhi berbagai bagian tubuh, terutama area-area hangat dan lembap seperti saluran kemih, organ reproduksi, tenggorokan, dan rektum.
Penularan Gonore
l Penularan utama gonore terjadi melalui kontak seksual, baik melalui hubungan seks vaginal, anal, atau oral dengan seseorang yang terinfeksi.
l Penularan juga dapat terjadi dari ibu yang terinfeksi kepada bayi saat proses kelahiran, menyebabkan konjungtivitis gonore pada bayi.
Penyebab Penyakit Kencing Nanah Atau Gonore
Gonore disebabkan oleh bakteri Neisseria gonorrhoeae. Bakteri ini dapat menginfeksi berbagai bagian tubuh, terutama area yang hangat dan lembap seperti saluran kemih, alat kelamin, tenggorokan, dan rektum.
Penularan gonore terutama terjadi melalui kontak seksual, baik melalui hubungan seks vaginal, anal, atau oral. Berikut adalah beberapa cara penularan utama gonore:
>>> Hubungi kami untuk konsultasi online, [ Gratis ]
1. Kontak Seksual Langsung
Penularan utama gonore adalah melalui kontak seksual langsung dengan orang yang terinfeksi.
Ini bisa termasuk hubungan seks vaginal, anal, atau oral. Jika salah satu pasangan memiliki infeksi gonore, risiko penularan kepada pasangan yang tidak terinfeksi sangat tinggi.
2. Penularan dari Ibu ke Bayi
Bayi yang lahir dari ibu yang terinfeksi gonore bisa mengalami infeksi pada mata, menyebabkan konjungtivitis gonore. Ini biasanya terjadi saat bayi melewati jalan lahir ibunya yang terinfeksi saat proses kelahiran.
3. Penyebaran melalui Benda Tertentu
Walaupun jarang, bakteri gonore dapat menyebar melalui benda-benda yang terkontaminasi dengan cairan tubuh yang terinfeksi. Namun, penularan ini lebih umum terjadi melalui kontak langsung kulit ke kulit selama hubungan seksual.
Penting untuk diingat bahwa gonore adalah penyakit menular seksual yang dapat menyebar dengan mudah.
Penggunaan kondom saat berhubungan seks dan membatasi jumlah pasangan seksual dapat membantu mengurangi risiko penularan dan penyebaran gonore.
Jika Anda memiliki kekhawatiran tentang kemungkinan infeksi gonore atau IMS lainnya, segera berkonsultasi dengan profesional kesehatan atau dokter spesialis penyakit menular.
Pemeriksaan dini, pengobatan yang tepat, dan tindakan pencegahan adalah langkah penting dalam mengelola gonore.
Konsultasi Gratis secara Online 24 Jam
Carilah referensi klinik untuk penyakit kelamin atau penyakit menular seksual terdekat. Dengan biaya terjangkau serta gratis layanan konsultasi secara online melalui Live Chat WA.
Klinik Spesialis Penyakit Kelamin ini memiliki dokter spesialis kulit kelamin serta staf medis yang berstandar internasional.
Pelayanan yang Kami berikan ramah dan memuaskan, sehingga pasien yang menjalani pengobatan pada klinik kami, serta alat medis yang canggih dan modern.
Bila memiliki penyakit menular seksual atau penyakit kelamin yang mengganggu, segeralah hubungi Klinik Utama Apollo pada nomor yang tertera diatas.
Disclaimer: Hasil dapat berbeda pada masing-masing individu.